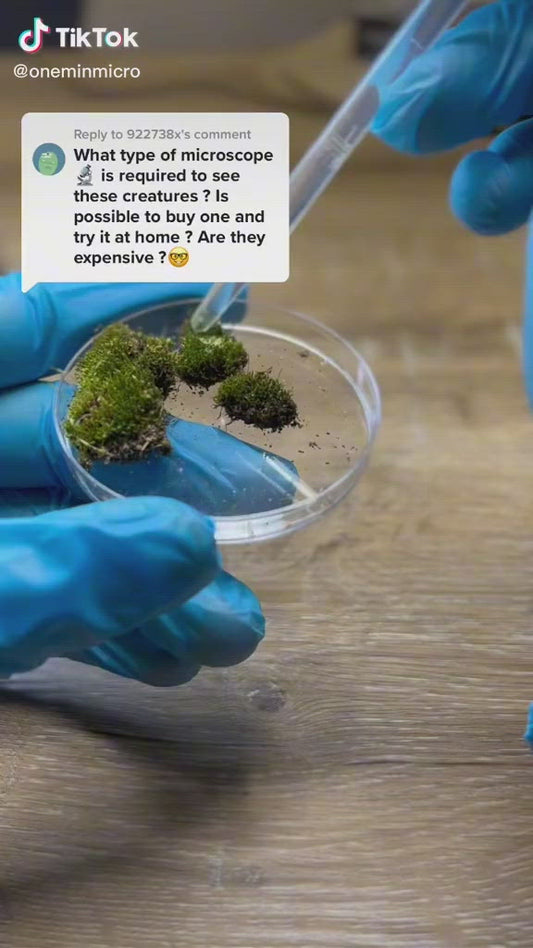
Carson MicroFlip™ 100x-250x LED, UV Lighted Pocket Microscope, Flip Down Slide Base, Smartphone Digiscoping Clip MP-250

-
Carson Mantaray™ 8x24mm BAK-4 High-Index Porro Prism Compact Binoculars MR-824
Regular price $99.90 SGDRegular priceUnit price per -
Carson MicroBrite™ Plus 60x-120x LED Lighted Zoom Pocket Microscope MM-300
Regular price $23.90 SGDRegular priceUnit price per -
Carson MicroBrite™ Pro 60x-120x LED Lighted Zoom Pocket Microscope with Smartphone Adapter Clip MM-350
Regular price $26.90 SGDRegular priceUnit price per -
Carson MicroFlip™ 100x-250x LED, UV Lighted Pocket Microscope, Flip Down Slide Base, Smartphone Digiscoping Clip MP-250
Regular price $29.90 SGDRegular priceUnit price per -
Carson MicroMini™ 20x LED Lighted Pocket Microscope with Built-in LED and UV Flashlight, Smartphone Digiscoping Adapter Clip MM-380
Regular price $25.90 SGDRegular priceUnit price per -
Carson MicroMini™ 20x LED Lighted Pocket Microscope, Built-In UV, LED Flashlight, Green MM-280G
Regular price $19.90 SGDRegular priceUnit price per -
Carson MicroMini™ 20x LED Lighted Pocket Microscope, Built-In UV, LED Flashlight, Orange MM-280O
Regular price $19.90 SGDRegular priceUnit price per -
Carson MicroPic™ 120x-240x Dual LED High-Resolution Pocket Microscope with Slide Base and Smartphone Digiscoping Clip MP-400
Regular price $29.90 SGDRegular priceUnit price per -
Carson MiniBrite™ 3x Power LED Lighted Slide-Out Aspheric Magnifier, Protective Sleeve PO-25
Regular price $19.90 SGDRegular priceUnit price per -
Carson MiniBrite™ 5x Power LED Lighted Slide-Out Aspheric Magnifier, Protective Sleeve PO-55
Regular price $19.90 SGDRegular priceUnit price per -
Carson MiniMight™ 6x18mm Pocket Monocular with Carabiner Clip MM-618
Regular price $29.90 SGDRegular priceUnit price per -
Carson MiniScout™ 7x18mm Porro Prism Ultra-Compact Lightweight Binoculars JD-718
Regular price $47.90 SGDRegular priceUnit price per -
Carson MonoPix™ 8x42mm Waterproof Monocular with Smartphone Digiscoping Adapter MP-842IS
Regular price $139.90 SGDRegular priceUnit price per -
Carson MonoZoom™ 7-21x21mm Zoom Monocular ZM-721
Regular price $47.90 SGDRegular priceUnit price per -
Carson Multi-Power LED Lighted Pocket Magnifier™2.5x, 4.5x and 6x PM-33
Regular price $19.90 SGDRegular priceUnit price per -
Carson Multipurpose COB LED Flashlight with Hook and Stand KL-20
Regular price $9.90 SGDRegular priceUnit price per -
Carson NeckLight Hardware Hands-Free Adjustable COB LED Light NL-20
Regular price $25.90 SGDRegular priceUnit price per -
Carson OvuScope™ Reusable Saliva Ovulation Fertility Prediction Microscope Test OS-100
Regular price $59.90 SGDRegular priceUnit price per -
Carson Pocket Micro™ 20x-60x LED Lighted Zoom Microscope MM-450
Regular price $23.90 SGDRegular priceUnit price per -
Carson PRO Series MagniVisor™ Deluxe Head-Worn LED Lighted Magnifier with 4 Lenses CP-60
Regular price $69.90 SGDRegular priceUnit price per -
Carson PRO Series MeasureLoupe™ 11.5x Power LED/UV Lighted Loupe Magnifier with Reticle CP-45
Regular price $45.90 SGDRegular priceUnit price per -
Carson RD Series 10x50mm Full-Sized Open-Bridge Waterproof Binoculars Green RD-050
Regular price $229.90 SGDRegular priceUnit price per -
Carson Safety Glasses +2.5 Diopter 1.6x Magnifier Flip-Up Scratch-Resistant Lens VM-20
Regular price $29.90 SGDRegular priceUnit price per -
Carson ScoutPlus™ 10x25mm Porro Prism Compact Lightweight Binoculars JD-025
Regular price $64.90 SGDRegular priceUnit price per